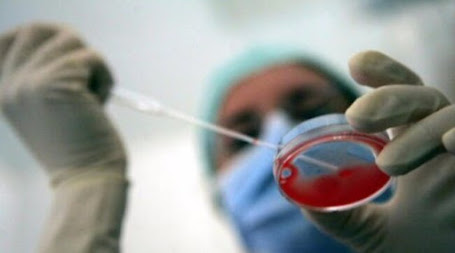

Antinfiammatorio, antiossidante e depurativo sono solo alcune delle proprietà benefiche della curcuma, ma occhio alle quantità assunte.
La curcuma è una spezia naturale di origine asiatica conosciuta da secoli per le sue straordinarie proprietà e sebbene non possa essere considerata un vero e proprio farmaco, sempre più studi e statistiche confermano le sue spiccate proprietà curative.
Le 7 proprietà della curcuma
La comunità medico-scientifica ha riconosciuto alla curcumina, ossia il principio attivo che dà il tipico colore giallo ocra al rizoma (fusto sotterraneo) e dal quale dipendono tutte le qualità benefiche della spezia, un potenziale alleato per la salute e il benessere dell’organismo.
Continua qui